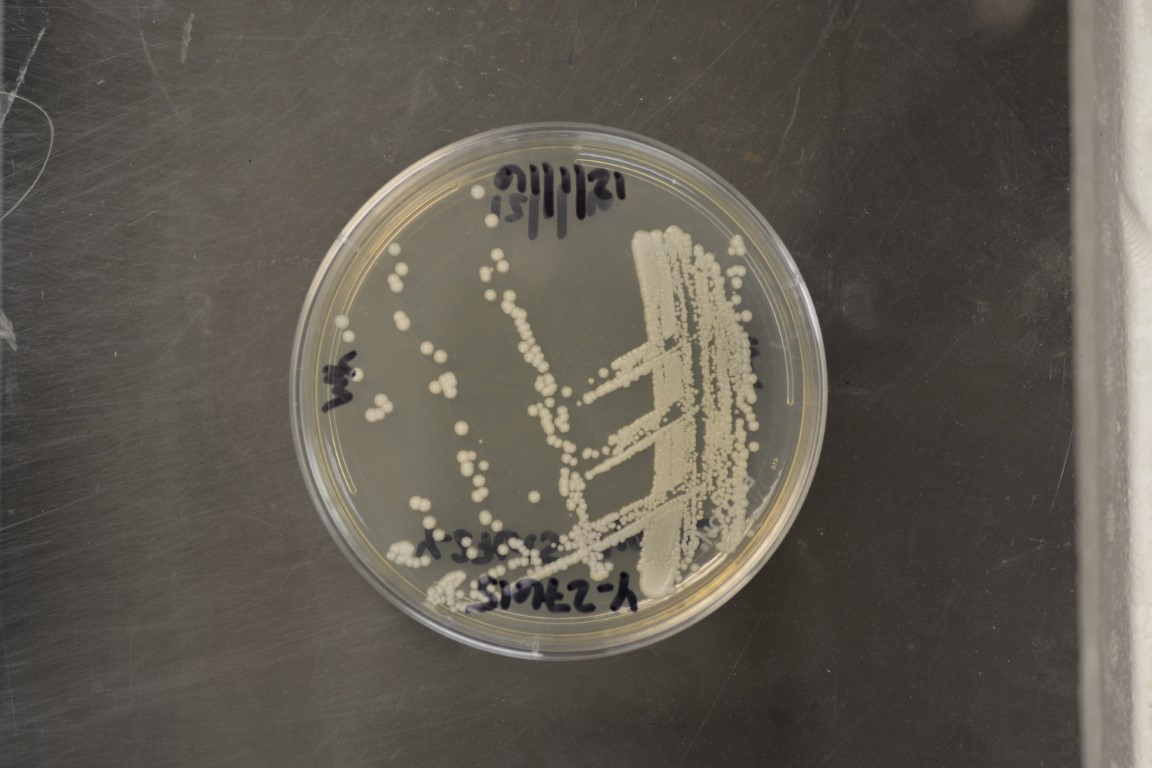

Metschnikowia chrysoperlae
NRRL Y-27615(Type Strain)
Accession numbers in other collections:CBS 9803=LSU Gibson-A
Source:Sung-Oui Suh,Louisiana State Univ.,Baton Rouge,LA
Isolated from(substrate):IN,eggs from adult lacewing Chrysoperla sp.
Substrate location:Tucson,Arizona,USA
Genetic info:GenBank:D1/D2(AY452047).
Growth media:Yeast Extract-Malt Extract-Peptone-Glucose(YM for yeasts)(number 6)
Optimum growth temperature:25C
Strain images:
NRRL_Y-27615_6.JPG

Comments:Int J Syst Evol Microbiol 54:1883-1890(2004).